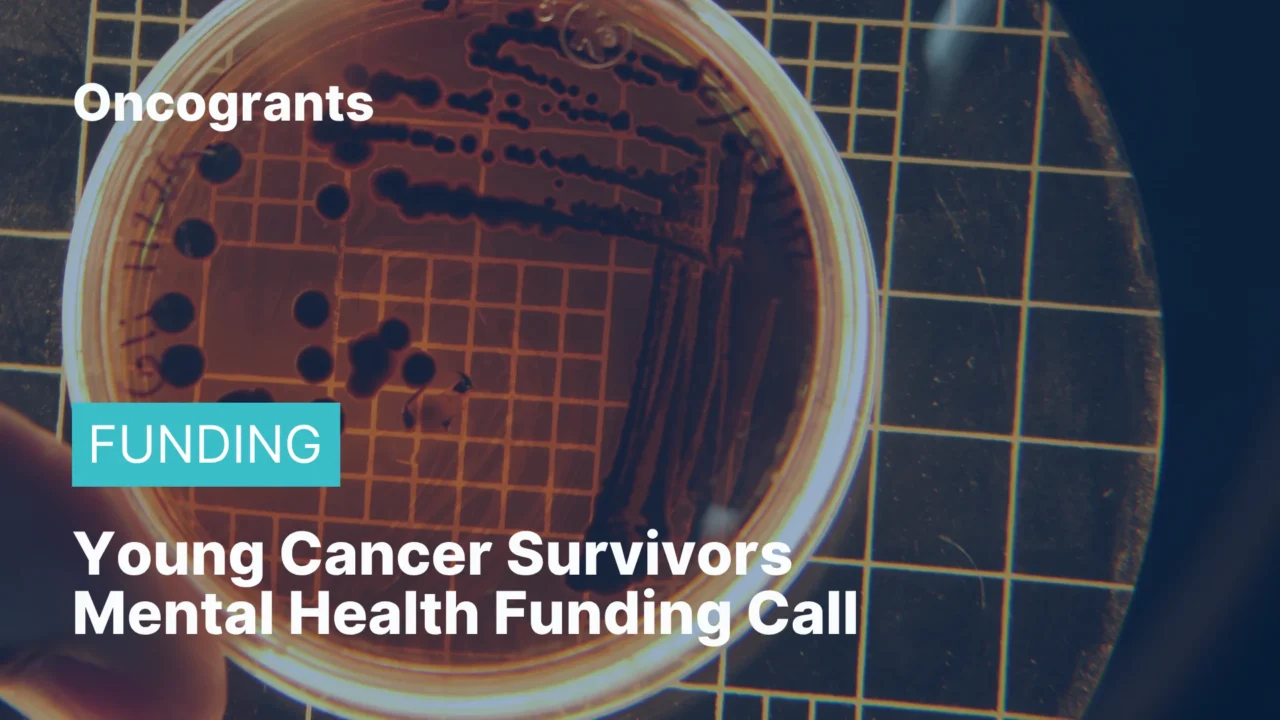
Young Cancer Survivors Mental Health Funding Call

This Innovation Action focuses on mental health support for adolescents and young adults (AYA) with cancer and survivors aged 15–39 at first diagnosis. The topic aims to build an online platform, integrated into the European Cancer Patient Digital Centre (ECPDC), that provides evidence-based and interactive tools to support mental health across diagnosis, treatment, and survivorship. The call is currently open and is one of the EU Cancer Mission’s specific quality-of-life actions for 2026.
Eligibility Criteria:
- Applications must be submitted via the EU Funding & Tenders Portal under Horizon Europe.
- Horizon Europe allows participation by legal entities from EU and associated countries, supporting collaborative innovation projects rather than US-only mechanisms.
- The portal notes that grants may go to eligible entities such as research organisations, NGOs, public entities, and companies.
- Detailed admissibility and eligibility are set in the Horizon rules and General Annex B.
Funding Details:
- Budget: €7,000,000.
- Type of action: HORIZON Innovation Actions (IA).
- The topic sits within the Cancer Mission call identifier HORIZON-MISS-2026-02.
Deadline:
- Opening date: 10 February 2026.
- Deadline: 15 September 2026.
- Status: Open for submission.
Where to go for further information (contact email or program details link)
- Official topic details: Boosting mental health of young cancer survivors through the ECPDC
- Official EU portal: EU Funding & Tenders Portal – HORIZON-MISS-2026-02